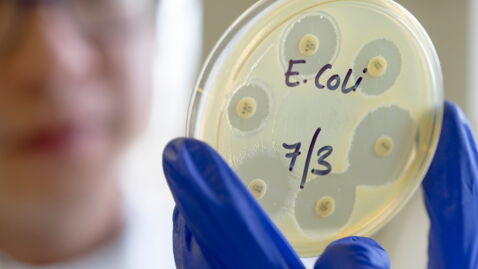
thumbnail

As per The Guardian, 37 people in 4 states of the United States of America fell sick with a dangerous strain of E.coli bacteria last week. The states in question are Indiana, Michigan, Ohio and Pennsylvania.
Discover our latest podcast
According to US Centers for Disease Control and Prevention (CDC), while not all E.coli strains are dangerous, some can be very harmful to humans, causing illness, diarrhoea and even illness outside the intestinal tract. E.coli spreads through contaminated food and water.
At least 37 people affected by E.coli outbreak in the U.S.A.
The Guardian reports that Wendy’s is one of the food joints which has been found to be possibly related to this dangerous outbreak. The suspected food for this contamination is the romaine lettuce in Wendy’s sandwiches.
The CDC has opened an investigation to find out the exact cause of the outbreak and whether the virus indeed contaminated Wendy’s romaine lettuce. The report quotes CDC officials as saying,
The true number of sick people in this outbreak is likely higher than the number reported, and the outbreak may not be limited to the states with known illnesses.
In response, Wendy's has removed romaine lettuce from its sandwiches in Michigan, Ohio and Pennsylvania where people were found to fall sick after eating at Wendy's.

Should consumers avoid Wendy’s lettuce?
According to the CDC, there is no solid evidence yet that Wendy’s lettuce is linked to the E.coli outbreak explains The Guardian. The CDC has also commented that it is not advising people against eating at Wendy’s or to stop eating romaine lettuce altogether.
However, Consumer Reports food safety experts have advised people to abstain from eating all Wendy’s products which contain romaine lettuce, including its salads, to minimise the risk of falling sick.
The report quotes, James E. Rogers, PhD, director of food safety and testing at Consumer Reports, who said
The goal is to minimize your risk of getting it, and until we know more about its source, it’s safest to avoid consuming Wendy’s sandwiches served with lettuce and any Wendy’s salad containing romaine lettuce.
Consumer Reports alsoquoted a statement by Wendy's that the company is:
Fully cooperating with public health authorities on their ongoing investigation of the regional E. coli outbreak reported in certain midwestern states.
Read more:
⋙ McDonald's in trouble?: Fast-food chain hit with complaints over size of burgers once again
⋙ This is what 'forever chemicals' found in fast-food wrappers do to your body














